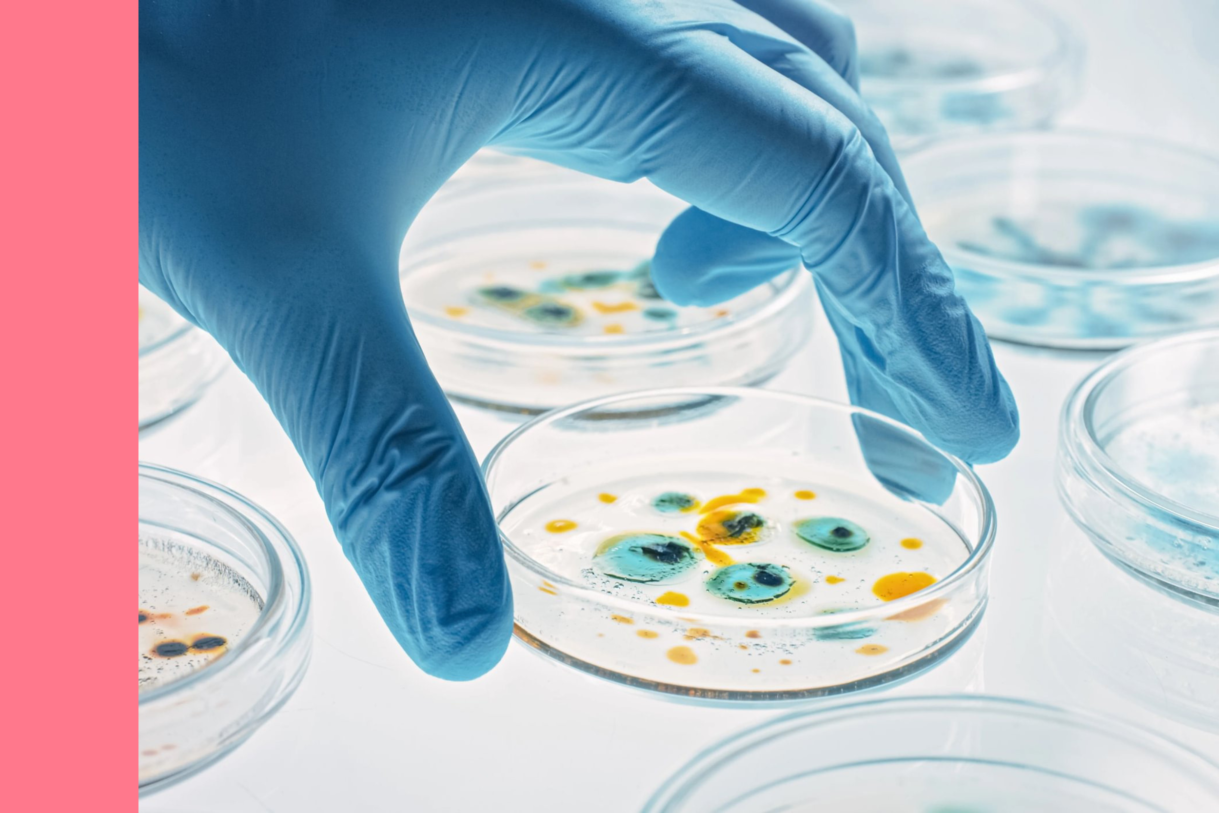
Gloved hand with petri dish

Our research
We fund and support the most promising health research wherever we discover great opportunities in areas that are underfunded.
We're facing up to the challenge of antimicrobial resistance and ensuring that we protect modern medicine for future generations.
Across hospitals and communities, infections are becoming harder to treat. Everyday illnesses are lingering, complicating recovery, and putting lives at risk. Antibiotics are losing their effectiveness as bacteria adapt and spread.
This is antimicrobial resistance (AMR): the rise of drug-resistant superbugs. It is accelerating at a pace we can’t afford to ignore. That’s why the Medical Research Foundation is investing in crucial research in this area.

We heard more about the challenge of AMR from Dr Wezi Sendama, who explained how his lung immunity research could reduce reliance on antibiotics.
Watch the recording
Learn more about antimicrobial resistance and the challenges it poses to the research community and the wider world.
Understanding AMR
We are inviting fellowship applications from early or mid-career researchers in the field of Antimicrobial Resistance research.
Find out about the funding
Delve into existing research that we have already funded to combat the rise of superbugs.
Our researchMost of us take antibiotics for granted and trust that they will work when we need them - that our chest infection will be treated, that routine surgery is safe and that antibiotics will do what they’ve always done since being put to use in modern medicine.
But that could be about to change.
And for some, it's already happening.
“My infection was resistant to treatment. Life threatening sepsis set in. My temperature soared. My blood pressure plummeted, and my heart pounded frantically in my chest as it pumped the infection through my veins. The surgeon’s face was grave."
For Laila, the awful reality of antimicrobial resistance meant an emergency operation and delays to her critical, impending cancer surgery.
Laila collaborated with Story Bug, a Foundation-funded project, to share her story and experience of antimicrobial resistance.

During her three-year intensive treatment for bowel cancer, 31-year-old Laila Hudson developed an antibiotic-resistant infection. Life threatening sepsis set in. Read Laila's story as she details her terrifying experience of dealing with a superbug.
Laila's storyJoin our list of email supporters and you'll be the first to hear about our research updates, including details of our newly funded work for AMR.